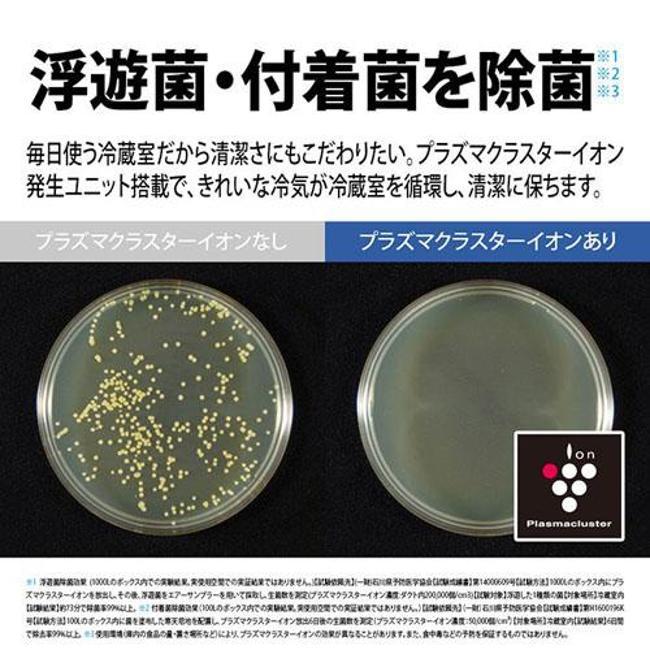
SHARP（シャープ） 冷蔵庫(501〜599L) 大型冷蔵庫 高品位ステンレス

マイストア
変更
お店で受け取る
(送料無料)
配送する
納期目安:
2026.02.25 16:28頃のお届け予定です。
決済方法が、クレジット、代金引換の場合に限ります。その他の決済方法の場合はこちらをご確認ください。
※土・日・祝日の注文の場合や在庫状況によって、商品のお届けにお時間をいただく場合がございます。
SHARP 6ドア 501L 大型冷蔵庫 ☆SHARP シャープ 501L 6ドア冷蔵庫 大容量 プラズマクラスター 冷凍の詳細情報
☆SHARP シャープ 501L 6ドア冷蔵庫 大容量 プラズマクラスター 冷凍。SHARP(シャープ) 冷蔵庫(501〜599L) 大型冷蔵庫 高品位ステンレス。SHARP 429L 6ドア冷凍・冷蔵庫 429L SHARP / シャープのレンタル。ご覧いただきありがとうございます。大型商品ですので搬入経路の確認は入念にお願いいたします。〈冷蔵庫の詳細〉シャープ2015年501L:動作確認済。清掃済。傷や汚れはございます。自動製氷確認済。嫌な臭いは感じませんでした。2015年式にしてはかなり状態は良いかと思います。型番:SJ-GT50A-Rサイズ:幅685㎜、奥行699㎜、高さ1820mm(搬入、設置は商品寸法+10㎝幅が目安です)以下一部抜粋・501Lの容量ながら、600Lクラス並の大容量冷凍室「メガフリーザー」を採用・「プラズマクラスター」で浮遊カビ菌・付着菌を除菌詳しくは型番からお調べください。〈自社配送関連〉大阪JR長居駅より20キロ圏内無料配送になります。なるべくご希望日時で調整させていただきます。関西県内など20キロ以上で自社配送をご希望の場合、50キロまで10キロ毎に2,000円の追加で対応できます。設置、接続に関しては使用できる状態まで対応させていただきます。2階以上は1階毎に2,000円の追加となります。特殊な搬入、取付は対応できませんのであらかじめご了承ください。①配送員1名+お手伝い1名は別途費用無(必ず持てる方でお願いいたします)②完全お任せ配送員2名は配送料8,000円。自社配送に限りリサイクル家電の有料回収対応可。ご購入前にご連絡ください。50キロ以上の遠方配送は梱包・発送たのメル便となります。〈返品対応に関して〉把握できている範囲で記載いたしますが、サイズ違い、傷、汚れ、臭いなどによる理由での返品はお受けできません。初期不良があった際は受取評価前(受取から3日以内)にご連絡いただければ対応させていただきます。お互い気持ちの良い取引となれば幸いです。ご不明な点はコメントお待ちしております。#冷蔵庫#シャープ#SHARP#大型#家電。SHARP(シャープ) 冷蔵庫(501〜599L) 大型冷蔵庫 高品位ステンレス。【動作OK!】JCM 卓上型対面冷蔵ショーケース【角型】JCMS-53T 冷蔵庫。冷蔵庫 洗濯機 家電セット 一人暮らし 東京 神奈川 千葉 埼玉 J18e1。A769♠️関西エリア配送設置可♠️冷蔵庫、洗濯機セット。118取付無料!2022年製三菱シンプルホワイトインテリア3ドア冷蔵庫!洗濯機。HOSHIZAKI 製氷機 IM-35。594 2023年製 三菱 大型冷蔵庫 300L強自動製氷 小型 家庭用 右開き。596 冷蔵庫 大型 400L〜500L 自動製氷機付 右開き 鏡面5ドア 格安。【配送・設置無料‼️】三菱電機 冷蔵庫 300L 24年製 自動製氷機能付き‼️。TOSHIBA 東芝 2024年製 ノンフロン冷凍冷蔵庫 GR-V33SC。三菱 冷蔵庫 冷凍庫 Mitsubishi MR-MB45。2022年製 冷凍冷蔵庫 エンゲル 車載38L MR040F。フォルスター ワインセラー ST-SV270G(P)-D。T89 三菱 冷凍庫。597 オススメ! 冷蔵庫 大型 400L〜500L 極美品 左開き自動製氷機付。TWINBIRD ツインバード 冷蔵庫 HR-EJ23 2025年製 美品。4ドア冷凍冷蔵庫 アイリスオーヤマ 320L IRSN-32B-S 2025年製。538 パナソニック 大型冷蔵庫 400L強 小型 家庭用 自動製氷 右開き。送料設置無料 Haier ノンフロン冷凍冷蔵庫 JR-CV34A。ホシザキ【ドロワー式】冷凍庫。540 冷蔵庫 大型 左開き 2024年製 訳アリ 一年保証付き ガラストップ。「A200」美品「2021年製」三菱 冷凍冷蔵庫 「MR-CG37G-H」3ドア。Coca-Cola 業務用冷蔵庫 保温/冷蔵 2方向式
ベストセラーランキングです
近くの売り場の商品
カスタマーレビュー
オススメ度 4.1点
現在、3461件のレビューが投稿されています。